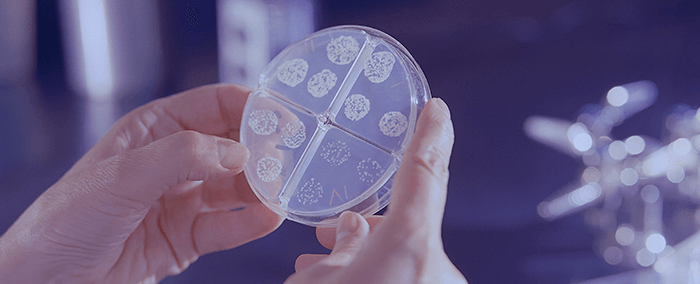
bacteries dans une boite de petri

Les facteurs et causes de la diarrhée
Pour commencer, définissons cliniquement la notion de diarrhée pour bien savoir de quoi l'on va parler dans cet article. Il s'agit de diarrhée quand un individu est atteint d’un trouble digestif accompagné d’une émission de selles liquides ou molles en quantité et en fréquence plus élevée que la normale. La diarrhée peut être aiguë ou chronique. On parle véritablement d’une diarrhée lorsque l’individu émet plus de 300g, plus de 3 fois par jour.
Pourquoi peut-on avoir une diarrhée ?
Tout se joue au moment de la digestion. À chaque étape de ce processus complexe, chaque organe joue un rôle bien spécifique. L’intestin grêle par exemple absorbe les glucides, les lipides et les protéines. Ce qui reste des aliments (également appelé résidu du bol alimentaire) passe alors dans le colon ou gros intestin.
C’est dans le colon que se joue une étape fondamentale : la réabsorption de l’eau. Cette étape va notamment permettre aux selles d’avoir une consistance suffisamment solide.

Principe de la réabsorption : l’osmose
Les parois intestinales permettent l’absorption des minéraux nécessaires au bon fonctionnement de l’organisme. Ces minéraux sont ainsi transportés de l’intérieur du colon vers les cellules intestinales. Pour assurer l’équilibre entre le sel de part et d’autre de la paroi intestinale, l’eau pénètre vers l’intérieur de l’organisme. Il s’agit de l’osmose.
Dans le cas d’une infection intestinale, ce processus est altéré. L’eau reste dans le colon et est évacuée dans les selles qui deviennent molles à liquides. C’est un épisode de diarrhée.
La diarrhée aiguë
Une diarrhée aigüe peut résulter d’une infection bactérienne (dans 80% des cas) ou virale ou encore de la présence d’un parasite dans l’organisme. Autre possibilité : une intolérance alimentaire ou médicamenteuse.
Les personnes les plus touchées par la diarrhée aigüe sont les voyageurs qui parfois consomment de l’eau non potable ou des fruits et légumes crus mal lavés ou non épluchés. Dans ce cas il est primordiale d’adapter son alimentation, de se mettre au repos et de bien s’hydrater dès les premiers symptômes. En règle générale, l’épisode passe rapidement et es selles retrouvent une consistance normale en quelques jours. Si la diarrhée est particulièrement handicapante au quotidien, il existe bien sûr des solutions médicamenteuses pour la juguler rapidement.
Si ce n’est pas le cas et que la diarrhée s’accompagne de fièvre et de douleurs abdominales, il est indispensable de consulter un médecin au plus vite.
La diarrhée chronique
On parle de diarrhée chronique lorsque l’épisode se prolonge et dure plus d’un mois.
La diarrhée chronique a plusieurs causes. Parmi elle on retrouve notamment les troubles de malabsorption. Le colon ne réabsorbe pas correctement l’eau. Ce trouble se manifeste particulièrement chez les personnes atteintes de la maladie cœliaque ou d’une pathologie inflammatoire chronique de l’intestin telle que la maladie de Crohn.
L’accélération du transit intestinale peut également être la source d’une diarrhée chronique. Lorsque les mécanismes de réabsorption n’ont plus le temps de se mettre en place, les selles deviennent plus liquides.
Quelques conseils alimentaires en cas de diarrhée
Il est important d’adopter un régime alimentaire adapté, notamment en cas d’épisode de diarrhée aigüe.
- S’hydrater suffisamment tout au long de la journée pour bien éviter la déshydratation.
- Consommer de préférence du riz ou des pâtes blanches. Soigneusement éviter les féculents à base de farine complète qui ont tendance à stimuler le transit.
- Manger léger en favorisant les bouillons de légumes bien cuits notamment la carotte.
- Privilégier une source de protéine à chaque repas même en petite quantité. On préférera les viandes blanches sans sauce telle que la dinde ou le poulet.
- Manger en fractionné plutôt que de faire de gros repas plus difficiles à digérer. Par exemple, il peut être intéressant de faire plusieurs petites collations au lieu des 3 repas quotidiens habituels.
- Ne pas consommer des sodas ou de boissons trop sucrées.